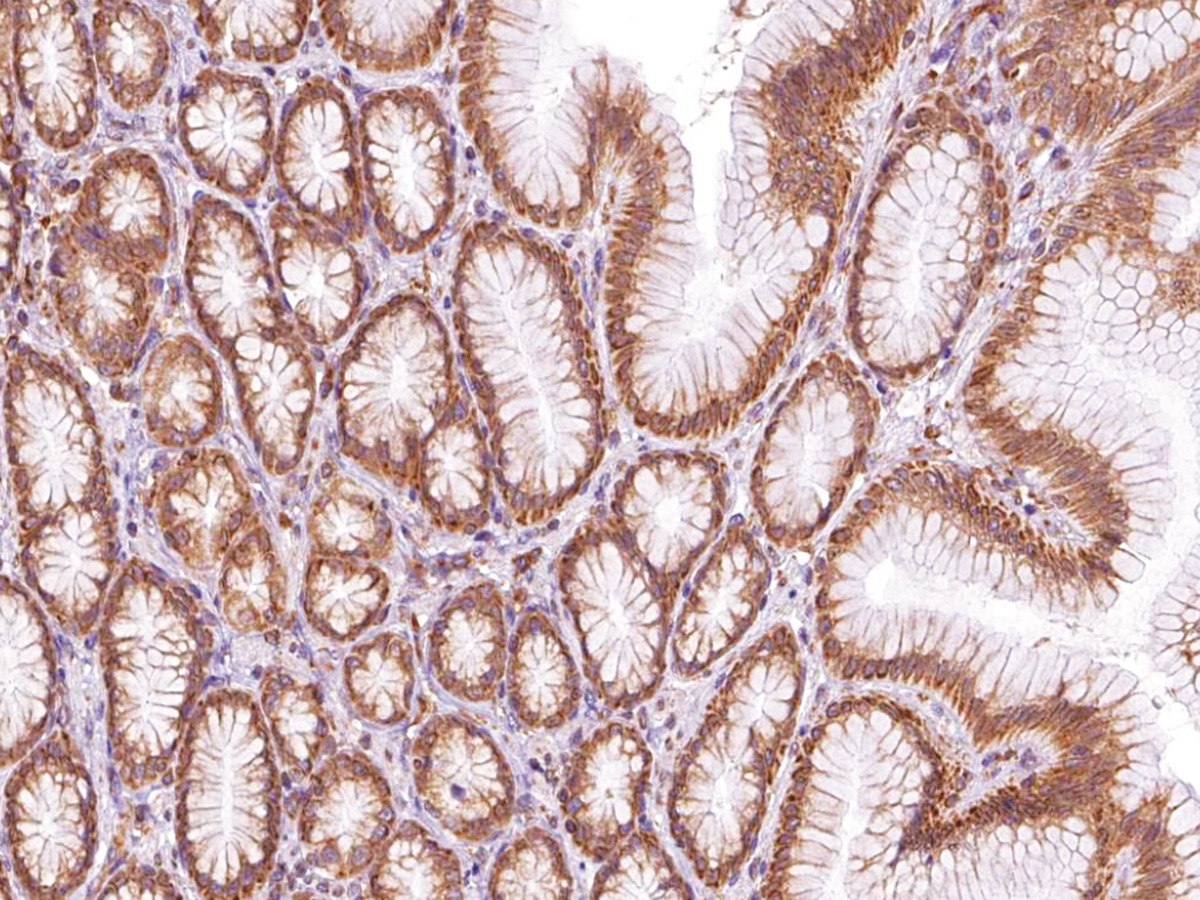
https://d1vffmuvmgkypt.cloudfront.net/image/ridacom_ltd/genomeme/PRODUCT_SOURCE__GENOME_ME__SUPPLIER__RIDACOM__ID__IHC507__0
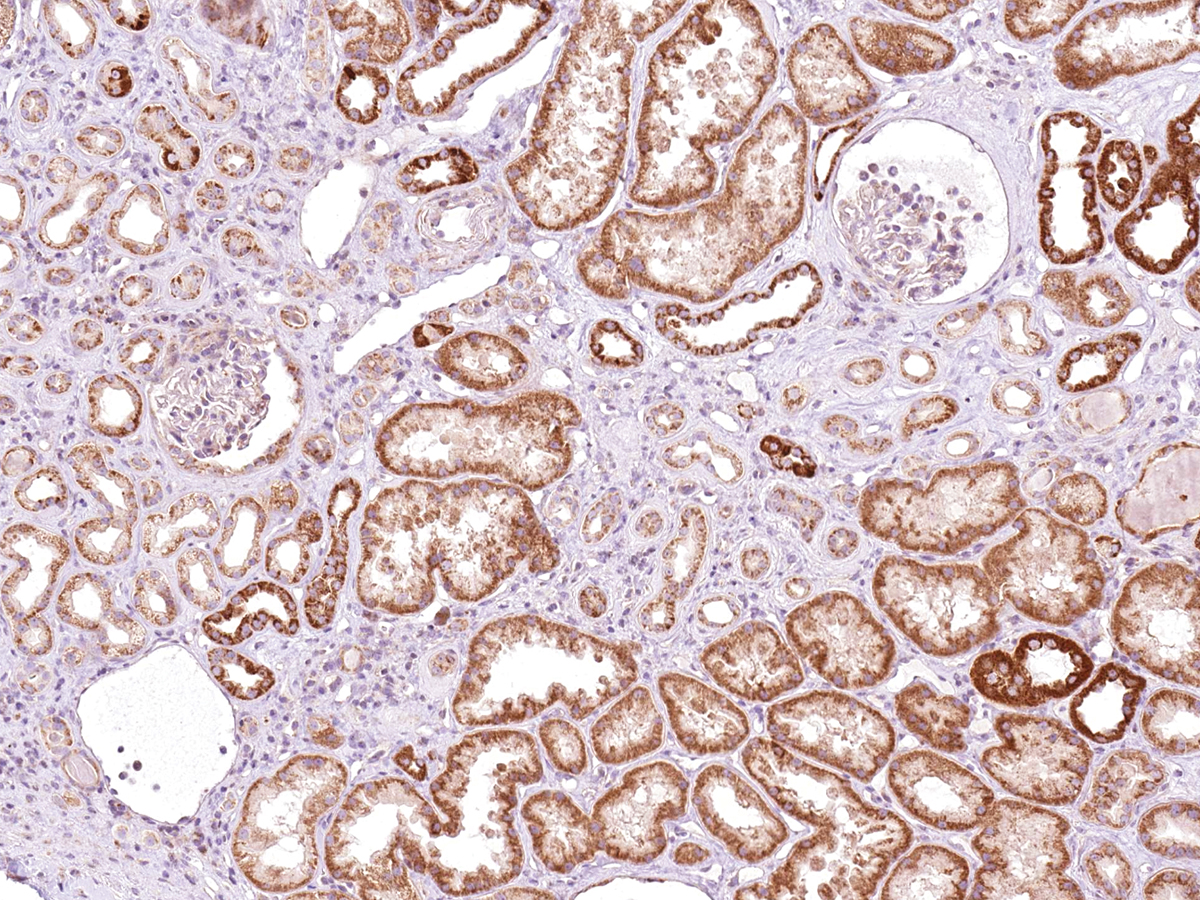
https://d1vffmuvmgkypt.cloudfront.net/image/ridacom_ltd/genomeme/PRODUCT_SOURCE__GENOME_ME__SUPPLIER__RIDACOM__ID__IHC413__0
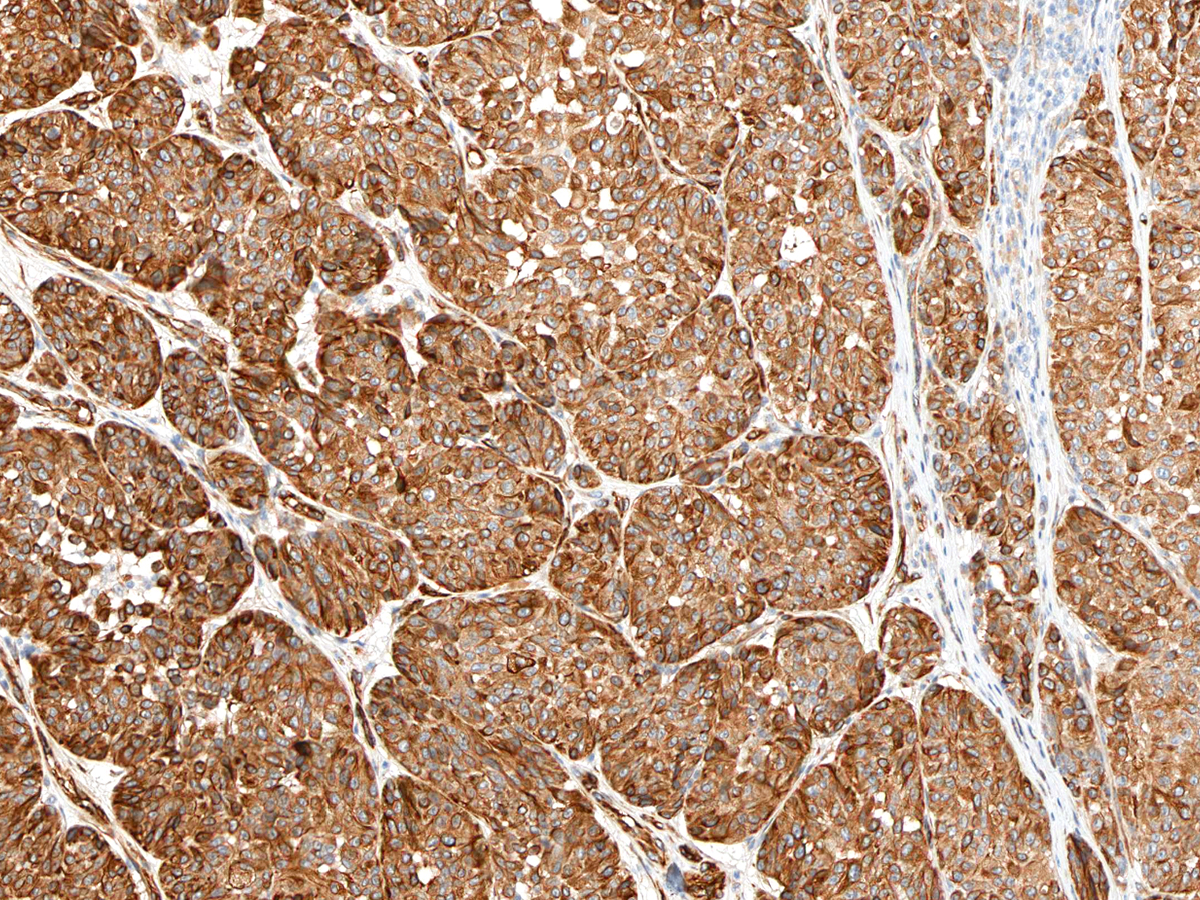
https://d1vffmuvmgkypt.cloudfront.net/image/ridacom_ltd/genomeme/PRODUCT_SOURCE__GENOME_ME__SUPPLIER__RIDACOM__ID__IHC638__0

Supplier
GenomeMe
Antigen
Sort
MLH1
(2)
ABCB11
(1)
ABCB4
(1)
ACTA2
(1)
AKR1B10
(1)
AMACR
(1)
Anxa1
(1)
B3GAT1
(1)
BRAF
(1)
BRD2
(1)
CD2
(1)
CD22
(1)
CD274
(1)
CD44
(1)
CD5
(1)
CDH17
(1)
CDH2
(1)
CDKN1A
(1)
CDX2
(1)
CEACAM5
(1)
CLU
(1)
COL4A1
(1)
CTLA4
(1)
DOG1
(1)
EGFR
(1)
FSHR
(1)
GATA3
(1)
GYPA
(1)
HAVCR2
(1)
IDH1
(1)
KRT18
(1)
KRT19
(1)
LMO2
(1)
LMP1
(1)
Lgals3
(1)
MDM2
(1)
MKI67
(1)
MSH2
(1)
MSH6
(1)
MTDH
(1)
MUC1
(1)
MUC16
(1)
MUC5AC
(1)
MUC6
(1)
MYC
(1)
Mapt
(1)
Myog
(1)
NCAM1
(1)
NKX2-1
(1)
Nanog
(1)
Host
Mouse
(87)
Rabbit
(1)


GenomeMe:
GenomeMe is a Canadian company established in 2015 with the mission to make medicine diagnostics more accessible and more precise. GenomeMe uses the most powerful DNA sequencing and quantification technologies and qPCR technology to create precise antigen design. The company offers immunohistochemistry (IHC) antibodies targeting the critical markers. For detection characterization and prognosis of cancer they create and commercialize novel IVD tools. GenomeMe guarantees quality, reproducibility and reliability in a fast paced environment. CMD/CSA ISO 13485:2003 and EN ISO 13485:2012 certified.
LMO2
$250.00

Antigen:
Rhombotin-2
Synonyms: Cysteine-rich protein TTG-2; LIM domain only protein 2; T-cell translocation protein 2; RBTN2_HUMAN; P25791; Q9HD58
Host:Mouse
Clonality:Monoclonal
Positive control:Tonsil; Follicular Lymphoma; Diffuse Large B-Cell Lymphoma
Dilution range:1:100 - 1:200
TFE3
$250.00

Antigen:
Transcription factor E3
Synonyms: Class E basic helix-loop-helix protein 33; TFE3_HUMAN; A8MZL6; P19532; Q5JU74; Q92757; Q92758; Q99964
Host:Mouse
Clonality:Monoclonal
Positive control:Testes; Melanoma; Xp11.2 Translocation Renal Cell Carcinoma
Dilution range:1:100 - 1:200
PMS2
$230.00

Antigen:
DNA mismatch repair protein MLH1
Synonyms: MutL protein homolog 1; Post meiotic segregation protein 2; MLH1_YEAST; D6VZY9; P38920; Q2I028; Q2I029; Q2I031; Q2I032; Q2I033; Q2I034; Q2I035; Q2I036; Q2I038; Q2I039; Q2I041
Host:Mouse
Clonality:Monoclonal
Positive control:Colon
Dilution range:1:100 - 1:200
p63
$220.00

Antigen:
Retinoid isomerohydrolase
Synonyms: All-trans-retinyl-palmitate hydrolase; Meso-zeaxanthin isomerase; Retinal pigment epithelium-specific 65 kDa protein; Retinol isomerase; RPE65_HUMAN; A8K1L0; Q16518; Q5T9U3
Host:Mouse
Clonality:Monoclonal
Positive control:Skin; Squamous Cell Carcinoma; Prostate
Dilution range:1:100 - 1:200
BSEP
$210.00

Antigen:
Bile salt export pump
Synonyms: ATP-binding cassette sub-family B member 11; Sister of P-glycoprotein; ABCBB_RABIT; Q9N0V3
Host:Mouse
Clonality:Monoclonal
Positive control:Liver
Dilution range:1:100 - 1:200
Hairy Cell Leukemia
$210.00

Host:Mouse
Clonality:Monoclonal
Positive control:Tonsil
Dilution range:1:100 - 1:200
Anti-Hairy Cell Leukemia stains various B-cells in the follicular mantle zone and virtually all cases of hairy cell leukemia. It also stains some high grade B-cell lymphomas.
MDR3
$210.00

Antigen:
Phosphatidylcholine translocator ABCB4
Synonyms: ATP-binding cassette sub-family B member 4; Multidrug resistance protein 3; P-glycoprotein 3; MDR3_HUMAN; A0A2V7; A4D1D3; A4D1D4; A4D1D5; D6W5P3; D6W5P4; P21439; Q14813
Host:Mouse
Clonality:Monoclonal
Positive control:Adrenal Cortex
Dilution range:1:100 - 1:200
N-cadherin
$210.00

Antigen:
Cadherin-2
Synonyms: CDw325; Neural cadherin; CADH2_HUMAN; A8MWK3; B0YIY6; P19022; Q14923; Q8N173
Host:Mouse
Clonality:Monoclonal
Positive control:Breast
Dilution range:1:100 - 1:200
TIM3
$210.00

Antigen:
Hepatitis A virus cellular receptor 2
Synonyms: T-cell immunoglobulin and mucin domain-containing protein 3; T-cell immunoglobulin mucin receptor 3; T-cell membrane protein 3; HAVR2_HUMAN; B2RAY2; Q8TDQ0; Q8WW60; Q96K94
Host:Mouse
Clonality:Monoclonal
Positive control:Tonsil
Dilution range:1:100 - 1:200
AEG1
$210.00
Antigen:
Protein LYRIC
Synonyms: 3D3/LYRIC; Astrocyte elevated gene-1 protein; Lysine-rich CEACAM1 co-isolated protein; Metadherin; Metastasis adhesion protein; LYRIC_HUMAN; Q05DH2; Q52QU9; Q6PK07; Q86UE4; Q8TCX3
Host:Mouse
Clonality:Monoclonal
Positive control:Glioblastoma
Dilution range:1:100 - 1:200
AKR1B10
$210.00

Antigen:
Aldo-keto reductase family 1 member B10
Synonyms: ARL-1; Aldose reductase-like; Aldose reductase-related protein; Small intestine reductase; AK1BA_HUMAN; A4D1P1; O60218; O75890; Q6FHF3; Q8IWZ1
Host:Mouse
Clonality:Monoclonal
Positive control:Hepatocellular Carcinoma
Dilution range:1:100 - 1:200
BRAF V600E
$210.00

Antigen:
Serine/threonine-protein kinase B-raf
Synonyms: Proto-oncogene B-Raf; p94; v-Raf murine sarcoma viral oncogene homolog B1; BRAF_HUMAN; A4D1T4; B6HY61; B6HY62; B6HY63; B6HY64; B6HY65; B6HY66; P15056; Q13878; Q3MIN6; Q9UDP8; Q9Y6T3
Host:Mouse
Clonality:Monoclonal
Positive control:Colorectal Adenocarcinoma; Thyroid Papillary Carcinoma with the BRAF V600E Mutation
Dilution range:1:100 - 1:200
CTLA-4
$210.00

Antigen:
Cytotoxic T-lymphocyte protein 4
Synonyms: Cytotoxic T-lymphocyte-associated antigen 4; CTLA4_HUMAN; A0N1S0; E9PDH0; O95653; P16410; Q0PP65; Q52MC1; Q53TD5; Q5S005; Q8WXJ1; Q96P43; Q9UKN9
Host:Mouse
Clonality:Monoclonal
Positive control:Tonsil; Lymph Node; Colon; Thymus
Dilution range:1:100 - 1:200
hENT1
$210.00

Antigen:
Equilibrative nucleoside transporter 1
Synonyms: Equilibrative nitrobenzylmercaptopurine riboside-sensitive nucleoside transporter; Nucleoside transporter, es-type; Solute carrier family 29 member 1; S29A1_HUMAN; B3KQV7; B3KQY5; Q5T9W9; Q99808; Q9UJY2
Host:Mouse
Clonality:Monoclonal
Positive control:Adrenal Cortex; Kidney; Thyroid; Tonsil; Normal Pancreas
Dilution range:1:100 - 1:200
SRRM4/nSR100
$210.00
Antigen:
Serine/arginine repetitive matrix protein 4
Synonyms: Medulloblastoma antigen MU-MB-2.76; Neural-specific serine/arginine repetitive splicing factor of 100 kDa; SRRM4_HUMAN; A7MD48; A8K5P6; B2RZH7; Q7Z5F0; Q96JH4
Host:Mouse
Clonality:Monoclonal
Positive control:Cerebellum
Dilution range:1:100 - 1:200
GATA3
$195.00

Antigen:
Trans-acting T-cell-specific transcription factor GATA-3
Synonyms: GATA-binding factor 3; GATA3_HUMAN; P23771; Q5VWG7; Q5VWG8; Q96J16
Host:Mouse
Clonality:Monoclonal
Positive control:Breast Carcinoma; Urothelial Carcinoma
Dilution range:1:100 - 1:200
Ki-67
$190.00

Antigen:
Proliferation marker protein Ki-67
Synonyms: Antigen identified by monoclonal antibody Ki-67; KI67_HUMAN; P46013; Q5VWH2
Host:Mouse
Clonality:Monoclonal
Positive control:Tonsil
Dilution range:1:100 - 1:200
c-Myc
$190.00

Antigen:
Myc proto-oncogene protein
Synonyms: Class E basic helix-loop-helix protein 39; Proto-oncogene c-Myc; Transcription factor p64; MYC_HUMAN; A8WFE7; P01106; P01107; Q14026
Host:Mouse
Clonality:Monoclonal
Positive control:Breast Carcinoma
Dilution range:1:100 - 1:200
Oct-4
$190.00

Antigen:
POU domain, class 5, transcription factor 1
Synonyms: NF-A3; Octamer-binding protein 3; Octamer-binding protein 4; Octamer-binding transcription factor 3; PO5F1_MOUSE; P20263; Q63843
Host:Mouse
Clonality:Monoclonal
Positive control:Seminoma
Dilution range:1:100 - 1:200
p40
$185.00

Host:Mouse
Clonality:Monoclonal
Positive control:Squamous Cell Carcinoma of Lung
Dilution range:1:100 - 1:200
p40 / ΔNp63 antibody was raised against a p40 specific epitope and can offer more specific detection than traditional p63 antibody in identifying lung squamous cell carcinomas. Although the frequently recommended squamous marker p63 is very sensitive, it suffers from low specificity due to reaction to subset of lung adenocarcinomas and lymphomas. Anti-p40 specially recognizes the N terminal truncated isoform of p63 (ΔNp63) that is demonstrated as more specific for squamous cell and basal cells. p40 and p63 are different in structure and exploit opposite functions. While p63 transactivates p53 and serves as a tumor processor, p40 inactivates p53 and promote the tumor progression. Studies support that Anti-p40 eliminates reaction with lung adenocarcinomas, thus offering higher specificity in lung squamous cell carcinomas.
PAX-8
$180.00

Antigen:
Host:Mouse
Clonality:Monoclonal
Positive control:Ovarian Carcinoma (Non-Mucinous Carcinoma); Thyroid Carcinoma; Renal Cell Carcinoma
Dilution range:1:100 - 1:200